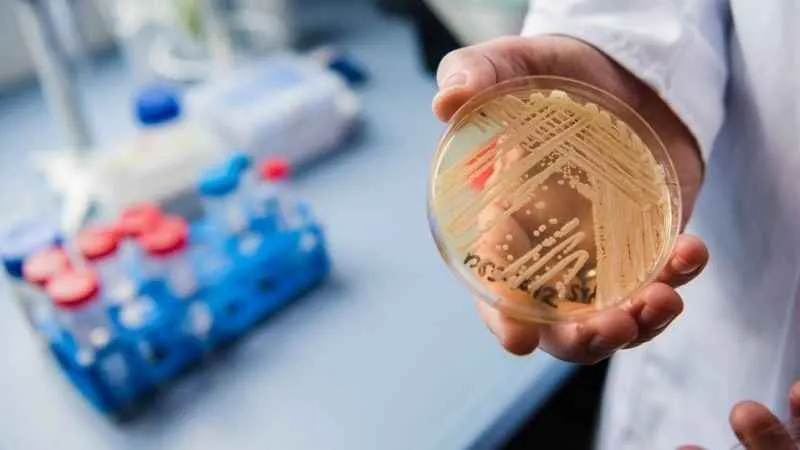
Yapay zeka ölümcül mantara karşı!

-
-
Yapay zeka ölümcül mantara karşı!Son dönemde özellikle yaygın hastane enfeksiyonlarına neden olan ve ilaçlara dirençli bir mantar türü “Candida auris”in antifungal ilaçlara karşı duyarlılığı yapay zeka kullanılarak belirlenecek.
-
Yakın Doğu Üniversitesi araştırmacılarının, Kasım 2022’de Antalya’da düzenlenen Türk Mikrobiyoloji Kongresi’nde yaptığı sunumların ardından, Türkiye ve KKTC’den üniversitelerin desteği ile ortak projeye dönüştürülen çalışma, Gazi Üniversitesi Bilimsel Araştırma Projeleri (BAP) çerçevesinde desteklenecek.
Projede, Gazi Üniversitesi Tıp Fakültesi Tıbbi Mikrobiyoloji Anabilim Dalı, gerekli olan DNA, RNA izolasyonu için güvenlik kabini, termal bloklar, DNA/RNA ölçüm cihazı ve spektrofotometre gibi altyapı olanaklarını sağlayacak. Karar ağacı oluşturulması ve yapay zeka destekli makine öğrenme basamağı ise Yakın Doğu Üniversitesi Sağlıkta Yöneylem Merkezi ve Uluslararası Kıbrıs Üniversitesi araştırmacıları tarafından gerçekleştirilecek.
Candida auris mantarı ilaçlara karşı dirençli
İnsanlarda ölümcül enfeksiyonlara neden olan Candida auris mantarı ilk kez 2009’da ABD’de keşfedildi. İlaçlara karşı dirençli olan bu mantar türü son yıllarda özellikle en korkulu hastane enfeksiyon kaynaklarından birine dönüştü. Maya olarak büyüyen bir tür mantar türü olan Candida auris, bir kez vücuda girdikten sonra kan dolaşımını, sinir sistemini ve birçok iç organı etkileyebiliyor. İlaçlara karşı dirençli olan Candida auris’in neden olduğu enfeksiyonlarda ölüm oranı ise Dünya Sağlık Örgütü (WHO) tarafından yüzde 30 ila yüzde 60 olarak tahmin ediliyor.
Yakın Doğu Üniversitesi araştırmacılarının de yer aldığı ortak proje ile teşhisi ve tedavisi oldukça zor olan Candida auris’in antifungal ilaçlara karşı duyarlılığını yapay zeka kullanılarak belirlenecek ve tedavi planı oluşturulması kolaylaştırılacak. Proje ile enfeksiyonların kontrolü, doğru dezenfektan kullanımının sağlanması ve antimikrobiyal direncin önlenmesi ile ilgili önemli sonuçlar hedefleniyor.
2022-2023 döneminde üçüncü ortak proje
Yakın Doğu Üniversitesi’nin Uluslararası Kıbrıs Üniversitesi ve Gazi Üniversitesi ile yürüttüğü Candida auris projesi 2022-2023 döneminde başladığı üçüncü ortak proje olma özelliği taşıyor. Yakın Doğu Üniversitesi, Celal Bayar Üniversitesi ile PCR Kit Üretim Laboratuvarı kurulumu için çalışma başlatmıştı. İstanbul Üniversitesi ile başlatılan proje ile de çocuklarda görülen, nadir metabolik hastalıkların genetik nedenlerinin saptanmasında tanı kitleri üretilecek.
Son dönemde bütün dünyada önemli bir sorun haline gelen Candida auris mantarlarının neden olduğu enfeksiyonlarla etkili bir şekilde mücadele edilmesi için yürütülecek projenin önemine değinen Yakın Doğu Üniversitesi Rektörü Prof. Dr. Tamer Şanlıdağ, “Yakın Doğu Üniversitesi olarak, oluşturduğumuz uluslararası iş birlikleri ile insanlık adına fayda sağlayacak projelerde yer almayı vizyonumuzun önemli bir parçası olarak görüyoruz” ifadesini kullandı.
Daha önce Celal Bayar Üniversitesi ve İstanbul Üniversitesi ile çok önemli iki projeyi hayata geçirmek için iş birliği yaptıklarını hatırlatan Prof. Dr. Şanlıdağ, “Ürettilen bilimsel bilgiyi insanlık yararına projelere dönüştürmeyi üniversite vasfının en önemli bileşenlerinden biri olarak görüyoruz. Bu nedenle gerek Türkiye’den gerekse dünyanın pek çok ülkesinden farklı üniversiteler ile iş birliği yaparak farklı alanlarda projeler geliştirmeye devam edeceğiz” dedi.

 Yorum yazarak topluluk kurallarımızı kabul etmiş bulunuyor ve tüm sorumluluğu üstleniyorsunuz. Yazılan yorumlardan Son Saat hiçbir şekilde sorumlu tutulamaz.
Yorum yazarak topluluk kurallarımızı kabul etmiş bulunuyor ve tüm sorumluluğu üstleniyorsunuz. Yazılan yorumlardan Son Saat hiçbir şekilde sorumlu tutulamaz.
-








Yorum Yazın